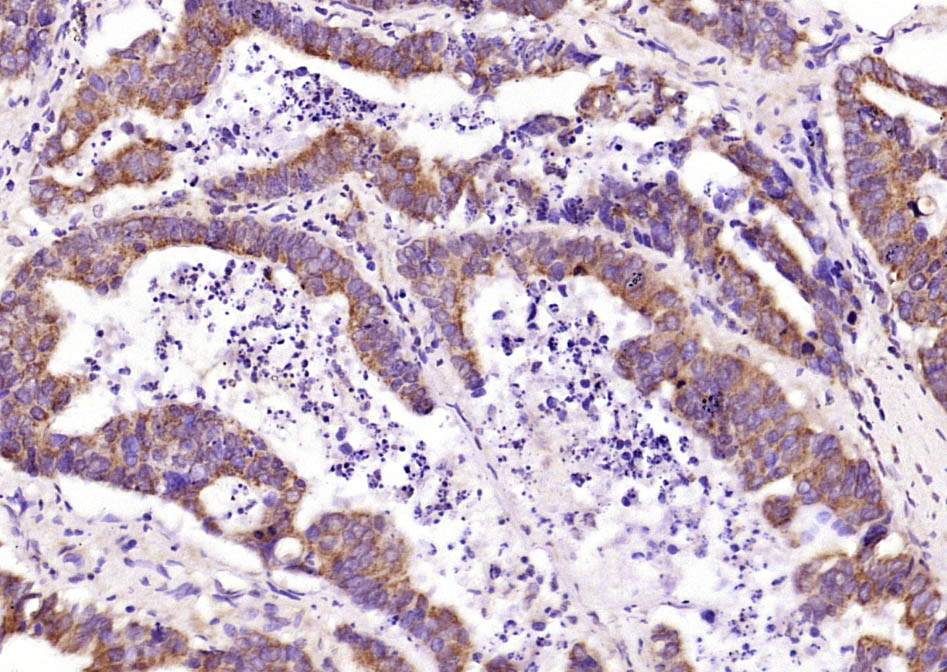
产品细节图片1

相关产品推荐更多 >

phospho-c-Jun (Thr91+Thr93) Rabbit pAb, Cy5 conjugated(bs-1735R-Cy5)-100ul
¥2980
Insulin (1G11) Mouse mAb, Biotin conjugated(bsm-0855M-Bio)-100ul
¥2980
BMP3 Rabbit pAb(bs-3663R)-50ul/100ul/200ul
¥1180
SLC40A1 Rabbit pAb, AP conjugated(bs-4906R-AP)-100ul
¥2980
TUBA1C Rabbit pAb(bs-5118R)-50ul/100ul/200ul
¥1180
万千商家帮你免费找货
0 人在求购买到急需产品
- 详细信息
- 文献和实验
- 技术资料
- 应用范围:
产品信息以Bioss网站为准
- 规格:
50ul/100ul/200ul
| 规格: | 50ul | 产品价格: | ¥1180.0 |
|---|---|---|---|
| 规格: | 100ul | 产品价格: | ¥1980.0 |
| 规格: | 200ul | 产品价格: | ¥2800.0 |
| 产品编号 | bs-22575R |
| 英文名称 | IKK gamma Rabbit pAb |
| 中文名称 | KB抑制蛋白激酶γ抗体 |
| 英文别名 | IkB kinase associated protein 1; IkB kinase subunit gamma; Inhibitor of nuclear factor kappa B kinase subunit gamma; AMCBX1; FIP 3; FIP3; Fip3p; I kappa B kinase gamma; IkB kinase associated protein 1; IkB kinase gamma subunit; IkB kinase subunit gamma; IKBKG; IKKAP 1; IKKAP1; IKKG; Incontinentia pigmenti; Inhibitor of kappa light polypeptide gene enhancer in B cells kinase gamma; Inhibitor of kappa light polypeptide gene enhancer in B cells, kinase gamma; Inhibitor of nuclear factor kappa B kinase gamma subunit; Inhibitor of nuclear factor kappa B kinase subunit gamma; IP 1; IP 2; IP; IP1; IP2; IPD2; NEMO; NF kappa B essential modifier; NF kappa B essential modulator; NF kappaB essential modifier; NF kappaB essential modulator; NFkappaB essential modulator. |
| 产品应用 | WB=1:500-2000, IHC-P=1:100-500, IHC-F=1:100-500, IF=1:100-500 Not yet tested in other applications. |
| 交叉反应 | Human (Mouse, Rat, Pig, Cow, Sheep) |
| 抗体来源 | Rabbit |
| 免疫原 | KLH conjugated synthetic peptide derived from human IKK gamma |
| 亚型 | IgG |
| 性状 | Liquid |
| 纯化方法 | affinity purified by Protein A |
| 克隆类型 | Polyclonal |
| 理论分子量 | 46 kDa |
| 浓度 | 1mg/ml |
| 储存液 | 0.01M TBS (pH7.4) with 1% BSA, 0.02% Proclin300 and 50% Glycerol. |
| 研究领域 | Cancer > Cell Death > Apoptosis > Apoptosis Markers > NFkB > IKK Cardiovascular > Atherosclerosis > Vascular Inflammation > Inflammatory mediators Cell Biology > Apoptosis > Intracellular > NFkB > IKK Epigenetics and Nuclear Signaling > Nuclear Signaling Pathways > NFkB pathway Immunology > Innate Immunity > TLR Signaling Signal Transduction > Protein Phosphorylation > Ser / Thr Kinases > Other Kinases Signal Transduction > Signaling Pathway > Nuclear Signaling > NFkB Pathway |
| 亚基 | Homodimer; disulfide-linked. Component of the I-kappa-B-kinase (IKK) core complex consisting of CHUK, IKBKB and IKBKG; probably four alpha/CHUK-beta/IKBKB dimers are associated with four gamma/IKBKG subunits. The IKK core complex seems to associate with regulatory or adapter proteins to form a IKK-signalosome holo-complex. The IKK complex associates with TERF2IP/RAP1, leading to promote IKK-mediated phosphorylation of RELA/p65. Part of a complex composed of NCOA2, NCOA3, CHUK/IKKA, IKBKB, IKBKG and CREBBP. Interacts with COPS3, CYLD, NALP2, TRPC4AP and LRDD. Interacts with ATM; the complex is exported from the nucleus. Interacts with TRAF6. Interacts with HTLV-1 Tax oncoprotein; the interaction activates IKBKG. Interacts with TANK; the interaction is enhanced by IKBKE and TBK1. Part of a ternary complex consisting of TANK, IKBKB and IKBKG. Interacts with ZFAND5. Interacts with RIPK2. Interacts with TNIP1 and TNFAIP3; TNIP1 facilitates the TNFAIP3-mediated de-ubiquitination of IKBKG (By similarity). Interacts with TNFAIP3; the interaction is induced by TNF stimulation and by polyubiquitin. Binds polyubiquitin; the interaction is mediated by two domains; reports about the binding to 'Lys-63'-linked and/or linear polyubiquitin, respective binding affinities and stoichiometry are conflicting. Interacts with Shigella flexneri ipah9.8; the interaction promotes TNIP1-dependent 'Lys-27'-linked polyubiquitination of IKBKG which perturbs NF-kappa-B activation during bacterial infection. Interacts with NLRP10. |
| 亚细胞定位 | Cytoplasm. Nucleus. Note=Sumoylated NEMO accumulates in the nucleus in response to genotoxic stress. |
| 组织特异性 | Heart, brain, placenta, lung, liver, skeletal muscle, kidney and pancreas. |
| 翻译后修饰 | Phosphorylation at Ser-68 attenuates aminoterminal homodimerization.
Polyubiquitinated on Lys-285 through 'Lys-63'; the ubiquitination is mediated by NOD2 and RIPK2 and probably plays a role in signaling by facilitating interactions with ubiquitin domain-containing proteins and activates the NF-kappa-B pathway. Polyubiquitinated on Lys-399 through 'Lys-63'; the ubiquitination is mediated by BCL10, MALT1 and TRAF6 and probably plays a role in signaling by facilitating interactions with ubiquitin domain-containing proteins and activates the NF-kappa-B pathway. Monoubiquitinated on Lys-277 and Lys-309; promotes nuclear export. Polyubiquitinated through 'Lys-27' by TRIM23; involved in antiviral innate and inflammatory responses. Linear polyubiquitinated on Lys-111, Lys-143, Lys-226, Lys-246, Lys-264, Lys-277, Lys-285, Lys-292, Lys-302, Lys-309 and Lys-326; the head-to-tail polyubiquitination is mediated by the LUBAC complex and plays a key role in NF-kappa-B activation. Polyubiquitinated on Lys-309 and Lys-321 via 'Lys-27'-linked ubiquitin by Shigella flexneri E3 ubiquitin-protein ligase ipah9.8, leading to its degradation by the proteasome. Sumoylated on Lys-277 and Lys-309 with SUMO1; the modification results in phosphorylation of Ser-85 by ATM leading to a replacement of the sumoylation by mono-ubiquitination on these residues. Neddylated by TRIM40, resulting in stabilization of NFKBIA and down-regulation of NF-kappa-B activity. |
| 相似性 | Contains 1 C2HC-type zinc finger. |
| 功能 | Regulatory subunit of the IKK core complex which phosphorylates inhibitors of NF-kappa-B thus leading to the dissociation of the inhibitor/NF-kappa-B complex and ultimately the degradation of the inhibitor. Its binding to scaffolding polyubiquitin seems to play a role in IKK activation by multiple signaling receptor pathways. Also considered to be a mediator for TAX activation of NF-kappa-B. Could be implicated in NF-kappa-B-mediated protection from cytokine toxicity. Involved in TLR3- and IFIH1-mediated antiviral innate response; this function requires 'Lys-27'-linked polyubiquitination. |
| 保存条件 | Shipped at 4℃. Store at -20℃ for one year. Avoid repeated freeze/thaw cycles. |
| 注意事项 | This product as supplied is intended for research use only, not for use in human, therapeutic or diagnostic applications. |
| 背景资料 | Pro inflammatory cytokines activate the transcription factor NF kappa B by stimulating the activity of a protein kinase that phosphorylates Ikappa B, an inhibitor of NF kappa B, at sites that trigger its ubiquitination and degradation. A large, cytokine responsive Ikappa B kinase (IKK) complex has been purified and the genes encoding 2 of its subunits have been cloned. These subunits, IKK alpha and Ikk beta, are protein kinases whose function is needed for NF kappa B activation by pro inflammatory stimuli. IKK is composed of similar amounts of IKK alpha, Ikk beta, which are differentially processed forms of a third subunit, IKK gamma. IKK gamma interacts preferentially with IKK beta and is required for the activation of the IKK complex. |
| 应用 | 推荐稀释比例 |
| {WB} | {1:500-2000} |
| {IHC-P} | {1:100-500} |
| {IHC-F} | {1:100-500} |
| {IF} | {1:100-500} |

Hela(Human) Cell Lysate at 30 ug
Jurkat(Human) Cell Lysate at 30 ug
K562(Human) Cell Lysate at 30 ug
Primary: Anti- IKK gamma (bs-22575R) at 1/1000 dilution
Secondary: IRDye800CW Goat Anti-Rabbit IgG at 1/20000 dilution
Predicted band size: 50 kD
Observed band size: 50 kD
风险提示:丁香通仅作为第三方平台,为商家信息发布提供平台空间。用户咨询产品时请注意保护个人信息及财产安全,合理判断,谨慎选购商品,商家和用户对交易行为负责。对于医疗器械类产品,请先查证核实企业经营资质和医疗器械产品注册证情况。
文献和实验[IF={{ 8.2 }}] {Jian Jin. et al. METTL3 enhances E. coli F18 resistance by targeting IKBKG/NF-κB signaling via an m6A-YTHDF1–dependent manner in IPEC-J2 cells. INT J BIOL MACROMOL. 2024 Mar;262:130101} {WB} {Porcine}
技术资料暂无技术资料 索取技术资料






